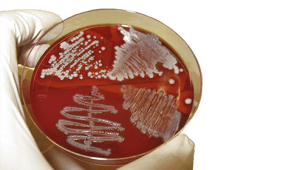
mileux de culture microbiologie tunisie

Milieux de cultures bactériologique SMSBio, fournisseur de milieu de culture en Tunisie, commercialise une large gamme de milieux de culture bactériologique et microbiologieque: Les peptones, Les extraits de viande, Les extraits de levures, Les liquides biologiques. Milieu de culture empirique Milieu de culture sélectif Milieu de culture enrichi Milieu ordinaire Milieu synthétique et semi-synthétique Bouillons de … Lire la suite de Milieux de cultures